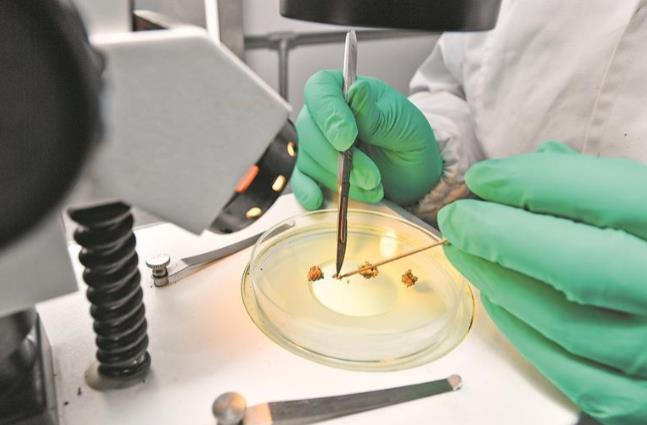

根據(jù)全國農(nóng)業(yè)技術(shù)推廣服務(wù)中心最新發(fā)布2024年度農(nóng)作物種植面積前十大品種的結(jié)果,青薯9號以49.8萬公頃的推廣面積,連續(xù)四年穩(wěn)居全國馬鈴薯種植面積榜首!在國家馬鈴薯產(chǎn)業(yè)技術(shù)體系、科研單位與企業(yè)的協(xié)同推動(dòng)下,青薯9號全國累計(jì)推廣面積突破533.33萬公頃,為保障國家糧食安全、農(nóng)牧民增收立下了汗馬功勞!
在青海,一粒看似普通的馬鈴薯,因被注入科技“芯片”,正深刻改變著整個(gè)產(chǎn)業(yè)的發(fā)展水平和質(zhì)量。優(yōu)質(zhì)脫毒種薯是推動(dòng)馬鈴薯產(chǎn)業(yè)高質(zhì)量發(fā)展的關(guān)鍵所在。在青海大學(xué)農(nóng)林科學(xué)院的實(shí)驗(yàn)室中,王艦教授帶領(lǐng)團(tuán)隊(duì)正借助解剖鏡,對馬鈴薯莖尖分生組織進(jìn)行一場精細(xì)如“心臟手術(shù)”般的操作。那個(gè)如同針尖般的組織,經(jīng)過精準(zhǔn)剝離、無菌培養(yǎng)與科學(xué)誘導(dǎo),最終煥發(fā)新生,育成一株健康的脫毒苗——這正是科技賦能農(nóng)業(yè)的生動(dòng)寫照。


這里沒有泥土的芬芳,卻孕育著廣袤土地上收獲的希望。
豐收的馬鈴薯,如何實(shí)現(xiàn)價(jià)值最大化?答案藏在三江集團(tuán)所屬的青海威思頓薯業(yè)集團(tuán)的全自動(dòng)加工車間里。粉條、淀粉、薯?xiàng)l、彩色薯片、生物科技飼料,這條不斷延伸的產(chǎn)業(yè)鏈,讓“藏糧于技”的戰(zhàn)略得到生動(dòng)詮釋。
這場華麗變身的背后,是強(qiáng)大的“科技芯”在提供源源不斷的核心驅(qū)動(dòng)力,為青海乃至全國農(nóng)業(yè)現(xiàn)代化發(fā)展,寫下一個(gè)熠熠生輝的范本。
(來源:青海日報(bào))















})